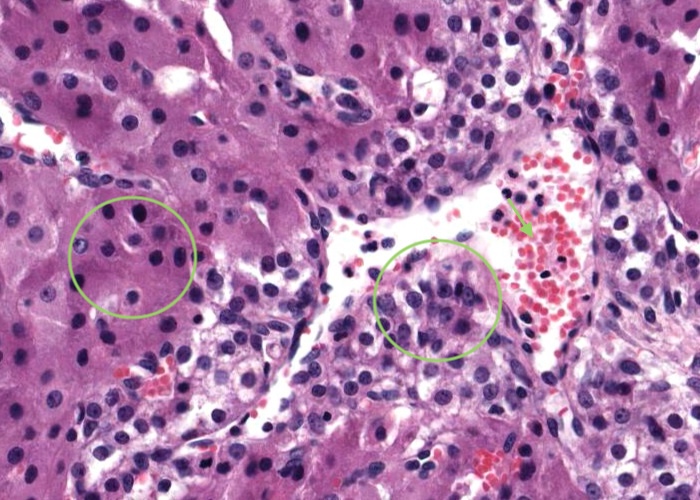
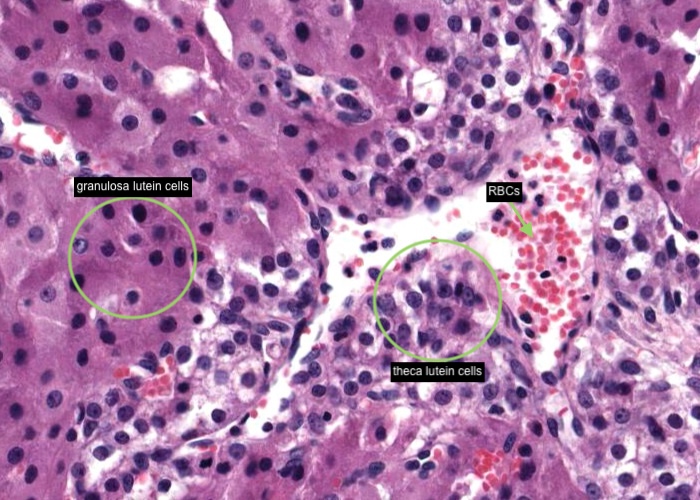
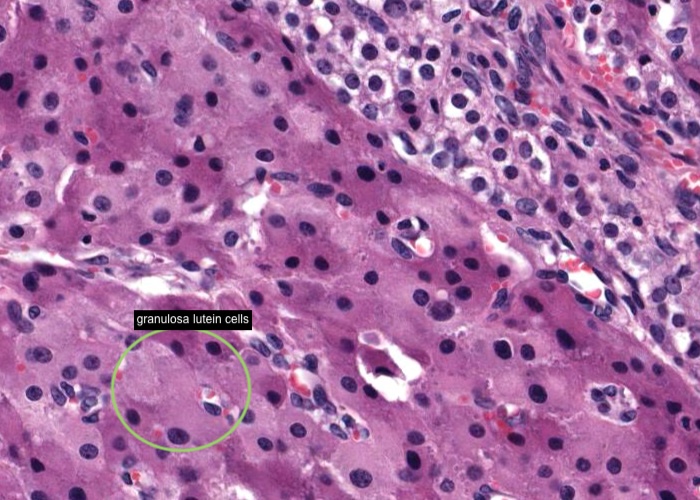

ANHB2214 Female Reproductive System
1/43
There's no tags or description
Looks like no tags are added yet.
Name | Mastery | Learn | Test | Matching | Spaced | Call with Kai |
|---|
No analytics yet
Send a link to your students to track their progress
44 Terms


This section makes it easy to appreciate that an ovary has a well defined cortex dominated by follicles and a medulla, dominated by blood vessels, which enter the ovary at the hilum. There are some pretty nice follicles to view in this section. Even at this low magnification, I can see a primary follicle and a secondary follicle even showing an oocyte. You will know how to do this also once you know the histological characteristics of follicular growth described in one of the items that follows under this heading.


Sections of ovary are often ovoid in shape and have a smooth external contour except at the hilum where blood vessels enter (and leave).
Microscopically, a layer of cuboidal cells called the "germinal" epithelium covers the surface of the ovary. The name is a poor one in that it has nothing to do with the germinal cells. Actually, this epithelium is just a mesothelial layer which, as a curiosity, is cuboidal instead of squamous.
When you view this section and can see where this covering is not visible, it was lost during histological processing. This epithelium is disrupted at each ovulation – and then is repaired.


A dense connective tissue capsule, the tunica albuginea, underlies the "germinal" epithelium. Deep to it the stroma of the ovary consists of a very cellular connective tissue. Its fibroblasts are large fusiform cells. When you view the section, blood vessels of varying size and plane of section are present, especially in the medulla in the centre of the ovary. Pools of red blood cells in the stroma are artifacts.
Look carefully in this image and spot the primary follicle - You will learn later why am I not calling it a primordial follicle.


Situated within the stroma of the cortex are small, medium and large follicles, each size representing a stage of development.
They are the key structures of the ovary.
They produce both the female gametes (haploid ovum = egg) and female sex hormones.
As a follicle gets bigger the chances that a random section through it will show the oocyte decreases, even though the oocyte is growing as well.
So do not be surprised that most large secondary follicles seem to lack an oocyte and cumulus oophorus.


Smallest follicles
dispersed in the outer cortex of the ovary under the tunica albuginea.
Each contains a primary oocyte encased in a single layer of squamous follicular cells and a surrounding basement membrane.
The oocyte has a large round, pale nucleus, prominent nucleolus, and abundant pale-staining cytoplasm.
These primordial follicles have been present in the ovary since before birth.


Primordial follicles are individually triggered to begin growing into a primary follicle by an unknown spontaneous mechanism.
At some random time the oocyte resumes its progression through meiosis and grows larger.
The follicular cells proliferate, enlarge into cuboidal cells and will crowd each other into several layers around the oocyte.
But, while the growing follicle still has a single layer of follicular cells it is termed unilaminar.
With further development it will be referred to as multilaminar.


The follicular cells proliferate, enlarge into cuboidal cells and crowd each other into several layers around the oocyte. This stratified epithelium in the primary follicle is now referred to as the membrana granulosa (stratum granulosum).
The growing follicle has now many layers of granulosa cells and so it is termed "multilaminar". There are two multilaminar follicles in this image.
A zona pellucida forms around the oocyte at about this transitional stage. This is a tough, eosinophilic, acellular, protective membrane between the oocyte and surrounding granulosa cells. Also, at this stage further follicular development becomes dependent on the pituitary hormone FSH. Surrounding the follicle a thin connective tissue sheet (the theca folliculi) begins to form.


A primary follicle moves deeper into the cortex and differentiates into a secondary follicle as follows:
Fluid–filled spaces open up within the mass of granulosa cells. These coalesce into a single antrum cavity.
The granulosa cells form a stratified cuboidal epithelium.
The oocyte becomes embedded in a thickened region of granulosa epithelium, called the cumulus oophorus, that projects into the antrum. A section may or may not cut through the oocyte.
Cells of the cumulus oophorus immediately adjacent to the oocyte are called the corona radiata.
The stromal cells (theca folliculi) arrange concentrically around the follicle, just outside the basement membrane, to begin to form the thecal layers.


The section missed the cumulus oophorus with the oocyte embedded in it. However, when you view this section, scan around the edge of the follicle and note the theca interna and theca externa are beautifully developed.
Outside these layers the cells are elongated having pulled apart from one another.
The gaps are artifacts but they let you see that the cells of the theca externa are spindle shaped and run parallel to one another.
This large follicle has grown and matured to the point that it may ovulate in response to a surge of the hormone LH from the pituitary.
It bulges at the periphery of the ovary as a mature follicle.
Its large cavity, or antrum, pushes the stratified granulosa cells to the periphery of the follicle.
The oocyte will be located at one side of the follicle and, if visible, appears buried in the cumulus oophorus a mound of granulosa cells and surrounded by the corona radiata.
Note the much smaller follicles in the lower edge of the image, particularly the size of a secondary follicle and so you can imagine the enormous growth involved to become a mature follicle.


The theca interna is the inner layer adjacent to the granulosa cell layer or, in this image, the antrum of the follicle filled with precipitated "liquor folliculi".
Cells in the theca interna are mostly cuboidal secretory cells with characteristics typical of steroid secreting cells as they manufacture androgens to be the precursors for estrogen synthesis.
Scattered amongst these cells will be fibroblasts, collagen and an extensive vascular system albeit too difficult to visualize in this image as the capillaries would have collapsed during the tissue processing.
The theca externa is the outermost layer consisting of collagen fibres and smooth muscle cells.


This is a rather large secondary follicle undergoing atresia. View this on the section and note apoptosis (= programmed cell death) of granulosa cells many of which are loose in the antrum.


When you examine the section you will observe that atretic follicles are abundant. Most of the mottling and texture that you see in the stroma of the ovary represent remains of old atretic follicles. These are follicles which developed partway and have then undergone degeneration.
Various progressive stages of atresia are seen in this image.
Many primary follicles begin to grow at each ovarian cycle. Only one (from the two ovaries) will complete maturation and ovulate. The others die off along the way. These atretic follicles take time to fully degenerate. They present a diversity of appearances for two reasons:
Follicles that have developed further before beginning to degenerate will give larger and more complex atretic forms. For example, secondary atretic follicles will have remains of the zona pellucida and perhaps thecal remnants, whereas follicles that began to degenerate as early primary follicles will not.
As atresia proceeds the follicles become more and more degenerate. In very old atretic follicles only a zona pellucida and maybe remains of the glassy membrane (which is formed from the basement membrane) are left.


At ovulation bleeding into the lumen of the ruptured follicle from disrupted capillaries in the thecal wall forms the "corpus haemorrhagicum". I think this is an early-formed corpus luteum and I am sure the follicle rupture site is at the top right of the image?
The corpus luteum (or luteal gland) is the mass of tissue that forms from a Graafian follicle after the ovum is expelled. This large structure mostly resembles a puckered up epithelial oval bag, with an internal cavity. The cavity is usually filled with loose connective tissue, and may have red blood cells and fibrin deposits in it resulting from hemorrhaging during ovulation. The wall of the corpus luteum consists of three layers – an inner layer of granulosa lutein cells, an irregular, thin, darker layer of theca lutein cells and an exterior capsule.

This thinner, irregular layer of theca lutein cells is derived from luteinization of the theca interna and appears much smaller, and more deeply stained, than granulosa lutein cells. Most have been pushed up into columns of cells under the folds of the granulosa lutein cells.
Remember the thecal layer is derived from the vascular theca interna layer of the Graafian/tertiary follicle. As blood capillaries (see erythrocytes in this large sinusoidal capillary) also collapse into the newly-formed corpus luteum they will under angiogenesis and vascularize the previously avascular granulosa cells in the granulosa luetin cell layer.

This inner, thick, stratified layer of granulosa lutein cells was formed by "luteinization" of the sheet of granulosa cells.
Under the influence of LH the granulosa cells divided and hypertrophied.
The resulting granulosa lutein cells are large, polygonal, pale-staining cells and filled with lipid droplets.
They stain palely because alcohol dissolves out the lipid during histological processing. After ovulation the basement membrane between the granulosa epithelium and the theca degenerated.
Capillaries then entered between the granulosa lutein cells.


The corpus luteum has an exterior capsule containing blood vessels. It immediately surrounds the theca lutein cells (as it is derived from the theca externa of the mature folllicle) and contains flattened fibroblasts and vascular channels. Small branches of these blood vessels, accompanied by some connective tissue, run from the capsule up through the columns of thecal lutein cells. They endow the corpus luteum with a rich vascularity typical of a formidable endocrine gland.


These bodies are scars that replaced the tissue of a corpus luteum when it degenerated. They appear as irregular, puffy, pink bodies composed of a mass of delicate collagen fibres. When you examine this section at high magnification you can see these fibres and the embedded nuclei of the fibrocytes that made them (as active fibroblasts).


The uterine tube (oviduct or Fallopian tube) is a long trumpet-shaped organ.
The histological section you can view (see the image above) is from a tissue block of an entire uterine tube that was dissected out and immersed in formaldehyde. It ended up twisted around so that when it was sectioned the blade cut through the tube several times in random orientations. You should see four or five sections through the tube. Most of the tissue is from the infundibulum, the large funnel-shaped segment adjacent to the ovary and opening into the peritoneal cavity, and you can see the margins are drawn out into numerous finger-like processes, the fimbrae.


Like most viscera with a lumen, the uterine tube has an outer serosa, muscularis and a mucosa which is very folded (mucosal folds).


The mucosal folds become much more elaborate towards the trumpet-shaped opening adjacent to the ovary. Trace out one of these folds in a circular section to appreciate how complex it is. Remember that what you are looking at is actually just a cross section through one amazingly elaborate longitudinal fold.


Focus on the simple epithelium of the folded mucous membrane (mucosa). You see a beautiful interspersion of broad, pale, ciliated cells and narrow, secretory cells (peg cells). In some places, the cilia show up superbly. Are basal cells present?


Glance at the underlying lamina propria and then check out the amount of smooth muscle in the muscularis wall. The muscularis consists of an inner, circular layer of smooth muscle and an outer, longitudinal layer of smooth muscle.


Under low magnification, determine the limits of the myometrium and endometrium. The perimetrium is not clearly present. When you examine this section, verify that the myometrium is comprised of bundles of smooth muscle cells separated by seams of connective tissue. You should also notice that many of the uterine arteries run in the outer regions of the middle part of this muscle layer.


The endometrium is a mucosa although the epithelium is missing over much of the surface due to harsh treatment when the organ was collected. The boundary of the endometrium with the myometrium is quite obvious but at this early stage in the menstrual cycle it is very difficult to draw the line between the basal and functional layers of this mucosa. The best indicator is the orientation of the glands. Those in the functional layer are running to the surface and therefore are cut longitudinally. The segments of the glands in the basal layer are convoluted, and so are sectioned in various orientations. But this criteria depends also on the orientation of how the section has been cut.
When you examine a histological section later see if you can find the coiled arteries of the endometrium. Think how corkscrew shaped arterioles should appear when sectioned.


Scan the section and you may find some of the remnants of the epithelium along the endometrial surface and note that it is similar to the epithelium of the glands. This is not surprising because the surface epithelium comes from the glands.
After the functional layer of the endometrium is shed during menstruation the surface is bare connective tissue. The ends of the glands remain in the basalis layer of the endometrium. Their cells divide rapidly and migrate out of the glands and over the surface of the endometrium. If you look carefully you may see a continuity of the two epithelia and can imagine the sheet of cells being pushed out of the glands.


The uterine endometrium imaged here is in the middle of the secretory (progesterone) phase. Notice its lacy appearance due to the development of the glands. These glands are actively secreting mucus and much of it remains inside the glands, enlarging them.
Now you can unambiguously distinguish the basal layer of the endometrium from the much thicker functional layer. The former is much more cellular. Also, parts of the glands in the basal layer have not become enlarged and tortuous. They remain much as they were during the follicular phase. When you examine the histological section, zoom in on the epithelium of the glands. Compare it with the epithelium lining the lumen of the uterus, pretty similar isn't it! If you look carefully you can see lymphocytes, neutrophils and eosinophils in the endometrium near the surface (with lymphocytes invading into the epithelium) but if you have not yet studied "Blood" this identification exercise is not necessary.
Locate the coiled arteries near the basal layer. Remind yourself of their special role in menstruation.
Why is this phase of endometrial development also called the luteal phase?


A straight artery nourishes the basal layer of the endometrium.


A spiral (coiled) artery supplies the stratum functionalis of the endometrium. These arteries constrict in response to progesterone and as a result the endometrium becomes ischaemic.


Verify that the myometrium is comprised of bundles of smooth muscle cells separated by seams of connective tissue. Many of the uterine arteries and large venous plexuses run in the middle part of this muscle layer (often referred to as the "stratum vasculare").


The large tongue-like projection into the vagina is the ectocervix. It has been left attached to a small segment of the posterior fornix of the vagina (to be more exact). The other lip of the cervix is missing.
When you view this section keep following the surface from the ectocervix to the surface of the cervical canal (endocervix) until it abruptly changes to a simple columnar (mucus-secreting) epithelium. The cervical mucosa has branching glands.
A trichrome stain would be nice here to distinguish collagen from smooth muscle within the wall of the cervix because both are important to cervical function.


The portion of the cervix projecting into the vagina is the ectocervix. Stratified squamous epithelium of the vagina extends over this outer, exposed wall of the cervix.


When you view this section keep following the surface until it abruptly changes from stratified squamous epithelium to a simple columnar (mucus-secreting) epithelium.
The abrupt point of transition between stratified squamous and simple columnar epithelium marks the entrance into the cervical canal (endocervix) and in women in reproductive age it is just outside the external os.


The cervical canal mucosa is thinner than the endometrium within the uterus and contains branching glands.
Spiral arteries are not present; this mucosa undergoes little change in thickness during the menstrual cycle and it not shed at menstruation.


This endometrium has numerous mucous glands. They are permanent, although the consistency of their mucous secretion varies over the menstrual cycle. It is particularly fluid in mid-cycle and at other times in the cycle the mucus is stickier.
The cervical glands, together with glands in the labia, also provide fluid to lubricate the vagina because, as we shall see in the next item, the vagina has no glands of its own.


The vagina is basically a fibromuscular tube of smooth muscle and collagen lined with a mucosa. At this low magnification you can distinguish the stratified squamous non-keratinized epithelium from the underlying connective tissue and surrounding smooth muscle as well as an outer adventitial layer which contains many elastic fibres.
The mucosa of the vagina is thrown into prominent transverse ridges, but these do not show up in this transverse section.


Look at the connective tissue when you view this section. Just below the epithelium it is quite cellular, as you would expect for a lamina propria and many of the cells are lymphocytes and leucocytes. However, there is no sharp boundary between this layer and the deeper markedly less cellular submucosa. Notice how vascular the connective tissue is here which helps to simulate erective tissue during sexual arousal.


The epithelial cells look swollen and empty as they move towards the surface. This is because they are filled with glycogen which leeches out during fixation. When the cells are desquamated (shed) from the surface, bacteria in the lumen ferment the glycogen in them. This keeps the pH low.


The underlying muscle layer has two or three sheets running in alternative orientations – an outer longitudinal layer and an inner circular layer (be sure you correctly view the section either transversely or longitudinally to make this judgement). The outer adventitial layer is dense connective tissue adjacent to the muscularis but becomes a looser connective tissue as it blends with other structures.
At first glance the vagina appears similar to that of the esophagus. The two are “classic histology look-alikes”, like smooth muscle and tendon or pancreas and parotid. However, the wall of the vagina has no glands, and the muscular portion is less well organized than that of the esophagus. There is no muscularis mucosa, nor striated muscle, anywhere along the length of the vagina.


The clitoris is the anatomical homologue of the more highly developed penis. The orientation may be somewhat confusing. This clitoris was sectioned obliquely, more longitudinally than transversely and sort of parallel to the overlying skin. The apical end of the organ is to the right. A fold of skin over the clitoris forms a "hood" homologous to the foreskin of the penis. This is why the covering epidermis seems to be located so far from the erectile tissue. Examine this skin and note it is similar to that over the labia minora, being lightly keratinized and with apocrine sweat glands, sebaceous glands, a few hairs, numerous minor blood vessels, and particularly, many small nerve bundles.
The clitoris is composed of only two columns of erectile tissue. These are homologous to the corpora cavernosa of the male penis but have the general architecture and erectile capabilities of the corpus spongiosum. Note the small, but abundant, cavernous sinuses and the relatively thin tunica albuginea, surrounding and separating the two columns of erectile tissue. The clitoris has no homologue of the corpus spongiosum. The urethra runs separately from the clitoris, reaching the surface behind that organ.


This tissue is from a prepubertal female. At this stage of development the gland consists almost entirely of ducts. True secretory units are not present. Nevertheless, the lobular organization is easy to see by eye at low magnification. The ducts identify the lobules which are surrounded by a less cellular interlobular connective tissue. The connective tissue contains numerous adipocytes (fat cells).
The prepubertal breast tissue does not differ markedly from the post-pubertal, nulliparous breast with regard to its glandular tissue. The big development at puberty is the formation of a large pad of adipose tissue. The distal parts of the mammary gland grow into this fat pad as they develop during pregnancy.


Excretory lactiferous ducts emerge in the nipple.
The nipple is conical and covered by keratinized stratified squamous epithelium continuous with that of adjacent skin (the areola). The colour of the areola darkens during pregrnacy as a consequence of accummulation of melanin. The epithelium is supported by a layer of connective tissue and if you examine this histological section you will find smooth muscle bundles within the connective tissue and also encircling the lactiferous ducts.


The ducts are embedded in intralobular connective tissue that is quite cellular. The lobules are surrounded by a less cellular interlobular connective tissue.


Compare the glandular tissue in this section with that in the non-lactating breast. Note that the lobules are greatly expanded due to the addition of more ducts and alveoli. The interlobular septa are thinner than in the resting (non-lactating) breast.


In the lactating mammary gland each lobule is greatly expanded due to the addition of more ducts and alveoli. The interlobular septum is thinner than in the resting breast.
It is difficult to tell the intralobular ducts from the alveoli because both are lined with secretory cells that secrete milk. Do not worry about distinguishing them. The ducts need larger lumens (and you can see some of these?) because they also store the milk between breast feedings.